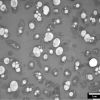

LVEM 25E là dòng Kính hiển vi điện tử truyền qua (TEM) nhỏ gọn và tích hợp tất cả trong một thiết bị. LVEM 25E là Kính hiển vi điện tử truyền qua điện áp thấp (LVEM) đầu tiên được trang bị EDS để phân tích nguyên tố, bổ sung cho các chức năng TEM, STEM, SEM và ED đã có trong tất cả các dòng máy trước đây.
LVEM 25E được biết đến là một TEM linh hoạt vì kết hợp đồng thời 3 chế độ hình ảnh với 2 chế độ phân tích. Thiết kế tiên tiến này cùng với với độ phân giải ấn tượng khiến LVEM 25E trở thành một đối tác xuất sắc sẵn sàng đáp ứng tất cả các yêu cầu về hình ảnh ở kích thước nano.
Ngoài ra, LVEM 25E được tối ưu hóa để phân tích các mẫu sinh học và polyme, rất phù hợp cho các ứng dụng trong nghiên cứu virus, giải phẫu bệnh v.v.

Tính năng nổi bật
-
Thiết kế tích hợp - Nhỏ gọn và linh động: Thiết kế hoàn toàn độc lập, giúp việc lựa chọn vị trí lắp đặt và di chuyển kính hiển vi điện tử một cách dễ dàng.
-
Thấu kính nam châm vĩnh cửu, không cần làm mát: Nền tảng LVEM 25E sử dụng thấu kính nam châm vĩnh cửu độc đáo, giúp cho thiết kế của thiết bị nhỏ gọn, mạnh mẽ, dễ sử dụng hơn và không cần hệ thống làm mát.
-
Khôi phục trạng thái chân không nhanh chóng và dễ dàng: LVEM 25E rút ngắn thời gian chết trong trường hợp mất chân không. Với chức năng điều chỉnh súng và Bakout tự động, việc khôi phục trạng thái chân không sẽ diễn ra nhanh chóng và không cần đến kỹ sư dịch vụ.
-
Hiệu chỉnh tự động - Tối ưu điều kiện chụp ảnh: Phần mềm tự động điều chỉnh, kiểm soát các vị trí, cùng với khẩu độ của cột LVEM 25E giúp người vận hành không cần phải điều chỉnh thủ công, cho phép chuyển đổi dễ dàng và nhanh chóng giữa các chế độ.
-
Thay đổi mẫu nhanh chóng - Hình ảnh thông lượng cao: Hệ thống chân không sử dụng bơm phân tử tích hợp và không cần bảo trì, kết hợp với bơm ion không rung, cho phép thay đổi mẫu siêu nhanh, tạo ra môi trường chân không siêu cao, không bị nhiễm bẩn.
-
Súng phát xạ trường với Độ tương phản cao nhất: FEG Schottky 25kV có độ sáng rất cao và độ kết hợp không gian cho phép diễn ra sự tương tác mạnh mẽ giữa các electron phát ra và mẫu. Điều kiện này mang lại cho LVEM 25E một độ tương phản cao, độc đáo.
Hình ảnh ứng dụng của LVEM 25E
(Vui lòng bấm vào hình để xem hình gốc)
Lĩnh vực Virus
Lĩnh vực Sinh học
Lĩnh vực Công nghệ sinh học
Lĩnh vực Miễn dịch học và Ung thư
Lĩnh vực Vật liệu nano
Liên hệ & Hỗ trợ

Tiếng Việt
日本語 (Japan)
한국어 (Korean)
中文 (Chinese)
English (UK)